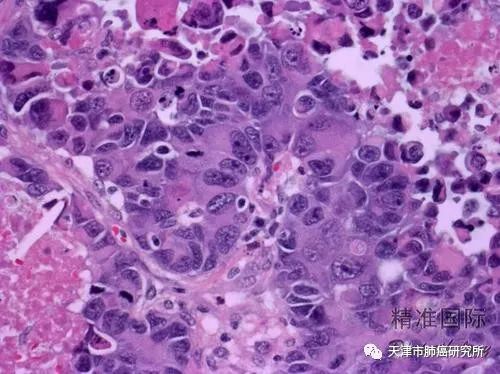

查看更多
密码过期或已经不安全,请修改密码
修改密码
壹生身份认证协议书
同意
拒绝
同意
拒绝
同意
不同意并跳过
作者:天津市肺癌研究所 朱帅 任凡
肺癌分型:
全球范围内,肺癌的发病率、死亡率都极高且呈上升趋势。2018年全球统计数据显示,男性肺癌发病率及死亡率均占恶性肿瘤的第1位。在女性人群中,肺癌的发病率位列恶性肿瘤的第3位,死亡率则仅次于乳腺癌,位列第二。
2015年我国统计数据显示,肺癌分别为男性和女性人群恶性肿瘤发病率的第一和第二位,而死亡率均居首位。其中,肺鳞癌的发病率近年呈下降趋势,约占肺癌的30%~40%;腺癌的发病率则呈上升趋势,约占肺癌的40%~55%。
(一)按肿瘤发生部位分型

⒈ 中央型:肿瘤发生于支气管或叶支气管,位于肺门附近的肺癌,约75%为鳞癌和小细胞肺癌。
⒉ 周围型:肿瘤发生在段以下支气管和肺泡的肺癌,在肺组织周边形成单个存在的结节状或球形结节,多为腺癌。

(二)组织学分型

常见有以下类型:
鳞状细胞癌(简称鳞癌)
鳞状细胞癌细胞大、呈多形、胞浆丰富、有角化倾向。多起源于段和亚段支气管,倾向于向气管腔内生长,常在早期导致气管狭窄、肺不张 、阻塞性肺炎,癌组织易发生坏死和空洞。多发生于50岁以上的男性。绝大多数患者有吸烟史。肿瘤发展较慢,转移较晚,以中央型居多。

腺癌
腺癌细胞不规则、核仁明显、胞浆丰富、常含黏液,是肺癌中最常见的类型,多表现为周围型。腺癌局部浸润,通过血液转移发生早,易累及胸膜引起胸腔积液。

小细胞癌
约占肺癌总发生率的15%,因癌细胞呈类圆形或梭形、细胞质少、体积小而得名。小细胞肺癌患者多为男性,与吸烟密切相关,是肺癌中恶性度最高的一种,小细胞肺癌增殖快、早期广泛转移,大部分患者在发现时即已出现全身转移,患者常因肺门肿块和纵隔肿大淋巴结引起的咳嗽和呼吸困难等症状而就诊。手术切除疗效差,但对放疗和化疗较为敏感

大细胞癌
是一种缺乏鳞癌、小细胞癌或腺癌形态特征的未分化癌。可发生于肺门附近或肺边缘的支气管,癌组织有出血和坏死倾向,转移较小细胞癌晚。
肺癌分期:

(一) 非小细胞肺癌(NSCLC)TNM分期
T用来描述肿瘤的直径大小。分为4类,分别为T0~T4。
T0:没有发现病灶。但有可能意味着在肺内层,存在着癌细胞的区域。
T1:在肺部内发现了病灶,根据肿瘤的直径分为T1a、T1b和T1c期。
T1a:癌症直径小于等于1 cm。
T1b:肿瘤直径介于1 cm到2 cm之间。
T1c:肿瘤直径介于2 cm到3 cm之间。
T2:肿瘤的直径介于3 cm到5 cm之间。T2分为T2a和T2b。
T2a:肿瘤直径介于3 cm到4 cm之间。
T2b:肿瘤直径介于4 cm到5 cm之间。
T3:癌症直径介于5 cm到7 cm之间,或者在肺叶上不止一个肿瘤,或者已经浸润了胸壁,肺部的神经,心脏(心包)的外层等。
T4:肿瘤较大,超过7 cm,或者在多个肺叶上发现了病灶,或者已经扩散到了附近的结节,或者扩散到了肺与纵隔之间。
N描述癌细胞是否扩散到淋巴结。
NX:不能对淋巴结进行评估,但并不意味着淋巴结不含癌细胞。
N1:癌细胞扩散到了肺连接气道的淋巴结。
N2:已经扩散到了纵隔以及气管附近的淋巴结。
N3:癌细胞已经扩散到了胸部、锁骨上淋巴结。
M代表癌细胞是否扩散及已经扩散的部位。
M0:癌细胞没有扩散。
M1:癌症已经扩散到身体的其他区域。它分为M1a、M1b、M1C。
M1a:下面的状况已经达到一个以上:1病灶已经在两肺内转移。2病灶转移到了心脏或肺的周围。3恶性胸腔积液或心包积液。
M1b:转移到了某个组织或器官,比如:肝脏、大脑或除淋巴结以外的其他区域。
M1C:意味着病灶已经发生了多处转移。
而判定肿瘤的分期,病灶是否转移是我们所考量的主要标准之一。
(二) 小细胞肺癌(SCLC)
⒈ 局限期:
病变限于一侧胸腔,有/无同侧肺门、同侧纵隔、同侧锁骨上淋巴结转移,可合并少量胸腔积液,轻度上腔静脉压迫综合征。
2. 广泛期: 凡是病变超出局限期者,均列入广泛期。
来源:天津市肺癌研究所
查看更多